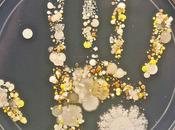
Voilà quoi ressemble bactéries main d’un enfant joué dehors

Taytay92i
 Description
Description
Je suis un Blogeur passionné par la Nouvelle Technologie http://GeekIrc.me #GeekIrc
MES BLOGS
-
GeekIrc
http://GeekIrc.me/
Désormais,vous pourrez retrouver toute l'actualité des jeux vidéo, mangas et high-tech
-
Actu-ipadiphone
http://Actu-ipadiphone.com/
Le high-tech Sur Le bout Des Doigts Sur…
DERNIERS ARTICLES (6084)
-
Test + jeu-concours : A gagner sur votre blog préféré, le ventilateur sur pied ...

Salut à toutes et à tous, Ça tombe bien avec la chaleur qu’il fait en ce moment… Je suis très heureux de vous dévoiler un nouveau « test » et en même temps... Lire la suite
Publié le 16 juin 2015 HIGH TECH, INFORMATIQUE -
Flyke : ce drone qui s’inspire á la fois d’un vélo et d’un vaisseau spatial !

C’est peut-être le moyen de transport de demain… Le Flyke est un nouveau-venu sur le secteur des drones et qui a été développé par une petite start-up en... Lire la suite
Publié le 15 juin 2015 HIGH TECH, INFORMATIQUE -
Serait-ce Nicolas Sarkozy en mode sexy dans ce dessin-animé japonais ?

Cette image a été découverte par un internaute et se répand à la vitesse de la lumière sur le web… Laissez tomber tout ce que vous êtes en train de faire parce... Lire la suite
Publié le 14 juin 2015 HIGH TECH, INFORMATIQUE -
Pendant ce temps là, en Russie, la société américaine Palcohol se prépare à...

Ah qu’est-ce qu’on rigole…. on l’a, la trouvaille du week-end ! La Russie, le pays où l’alcool coule à flot, où l’impossible devient possible…... Lire la suite
Publié le 14 juin 2015 HIGH TECH, INFORMATIQUE -
Les poils sous les aisselles sont la dernière tendance sur #Instagram

Qu’on se le dise franchement, ce samedi, comme tous les samedis et ça depuis quelques temps déjà, c’est l’article détente sur votre blog préféré et ça, c’est... Lire la suite
Publié le 13 juin 2015 CÔTÉ FEMMES -
Des scientifiques américains ont créé la première patte biologique de rat...

Il s’agit là d’une belle prouesse et le progrès fait de nouveau parler de lui. Ainsi, une équipe de scientifiques du General Massachusetts Hospital de Boston es... Lire la suite
Publié le 13 juin 2015 HIGH TECH, INFORMATIQUE -
Infographie : en savoir un peu plus sur les différents ingrédients pour...

Ce n’est un secret pour personne, le « burger » se porte bien et il fait même des millions d’adeptes à travers le monde. Et autant vous le dire de suite, ce... Lire la suite
Publié le 12 juin 2015 HIGH TECH, INFORMATIQUE -
R2-D2 peut désormais vous apporter vos boissons fraîches sans le moindre effort !

Une chaude journée au boulot ? Envie d’une bonne boisson pour vous rafraîchir ? Dès l’approche de l’été, plusieurs questions viennent à l’esprit. Vivement les... Lire la suite
Publié le 11 juin 2015 HIGH TECH, INFORMATIQUE -
HydrateMe : la première bouteille d’eau intelligente !

Les objets connectés marchent fort, c’est un fait ! Et ça depuis quelques temps déjà, et le phénomène n’est pas prêt de s’arrêter bien au contraire. Lire la suite
Publié le 10 juin 2015 HIGH TECH, INFORMATIQUE -
Le premier restaurant #HelloKitty ouvre ses portes à Hong Kong !

Vous connaissez forcément ce personnage si vous avez des filles à la maison. J’en sais quelque chose…Hello Kitty, ce chat au ruban rouge, connu dans le monde... Lire la suite
Publié le 10 juin 2015 HIGH TECH, INFORMATIQUE -
Voilà à quoi ressemble les bactéries sur la main d’un enfant qui a joué dehors !
Il n’y a rien de pire que les bactéries ! Et il faut toujours se laver les mains… Les bactéries, ce sont de vraies saloperies très faciles à attraper. Lire la suite
Publié le 10 juin 2015 HIGH TECH, INFORMATIQUE -
Cette voiture ne démarrera pas si vous avez trop bu !

Qu’on se le dise, en voilà une bonne invention… J’espère que vous allez bien avec ces grosses chaleurs ! Pour ma part, la chaleur ne m’atteint pas puisque je... Lire la suite
Publié le 09 juin 2015 HIGH TECH, INFORMATIQUE -
Après quelques semaines à porter la montre connectée Pebble Steel, voici le...

Salut à toutes et à tous, La Pebble s’est fait connaître par l’intermédiaire d’une campagne KickStarter et ce fut une belle réussite ! Lire la suite
Publié le 08 juin 2015 HIGH TECH, INFORMATIQUE -
L’Ecocapsule : la maison du futur pour vivre un peu n’importe où !

En commençant à rédiger ce petit article, je ne sais pas pourquoi mais j’ai tout de suite pensé à « Dragon Ball Z » et croyez-moi ça va être la même chose pour... Lire la suite
Publié le 07 juin 2015 HIGH TECH, INFORMATIQUE -
Des chercheurs suédois viennent de mettre au point un calculateur capable de...

On l’a, la trouvaille du week-end… Que feriez-vous si vous étiez capable de connaître l’âge où le moment est venu de rejoindre l’autre monde ? Ne... Lire la suite
Publié le 06 juin 2015 HIGH TECH, INFORMATIQUE -
Découvrez le couteau ultra-léger et personnalisable de Deejo !

Salut à toutes et à tous, Je profite de ma pause-café au soleil, pour vous présenter encore une fois une nouvelle découverte qui devrait en faire craquer plus... Lire la suite
Publié le 05 juin 2015 HIGH TECH, INFORMATIQUE -
Test Flash : coque BlackBerry Classic Soft Shell – Noire Translucide

Salut à toutes et à tous, Aujourd’hui, on se retrouve pour un test flash ! Cette fois-ci, j’ai craqué une nouvelle fois pour une coque pour le Blackberry Classi... Lire la suite
Publié le 04 juin 2015 HIGH TECH, INFORMATIQUE -
Ce réveil va vous sortir du lit avec une délicieuse odeur de café !

Un exploit réalisé par un français… L’été s’installe peu à peu sur le territoire et avec lui, les siestes vont se multiplier. Le réveil est parfois difficile,... Lire la suite
Publié le 03 juin 2015 HIGH TECH, INFORMATIQUE -
Fast and Furious 8 : Vin Diesel dévoile une affiche et confirme New York pour l...

Et hop, des filles légèrement vêtues, des voitures à couper le souffle et de l’action à gogo… On le sait tous, Vin Diesel ne sais pas garder les... Lire la suite
Publié le 02 juin 2015 HIGH TECH, INFORMATIQUE -
La boîte à pizza qui se transforme en vidéo projecteur !

Là, c’est sûr, on tient sans doute l’une des plus belles boîte à pizza de l’année… Encore une belle invention que tous les fans de pizza du monde entier vont... Lire la suite
Publié le 02 juin 2015 HIGH TECH, INFORMATIQUE
